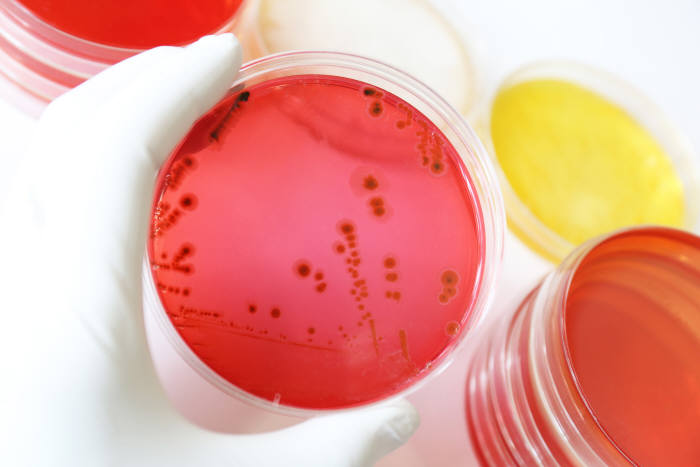
Photo Image

소비자 식중독 불안을 키운 냉장·냉동 케이크류에 대해 식품안전 전문가들이 스마트 HACCP(해썹)과 지능형온도스티커(TTI) 도입을 촉구했다.
최근 충북 청주와 진천 급식소에서 발생한 집단 식중독 사고로 총 256명의 환자가 발생했고 식품의약품안전처는 문제의 딸기크림 롤케이크와 초코바나나빵 판매를 중단시켰다. 이는 2018년 전국 55개 학교에서 2200명 이상이 식중독에 걸린 초코케익 사태를 연상케 한다.
한국식품안전연구원, 한국식품위생안전성학회, 한국식품안전협회 등 산학연 단체는 “냉장·냉동 유통제품의 유통 온도와 시간 관리가 미비하면 살모넬라균이 급격히 증식해 식중독을 일으킬 수 있다”며 과학적 온도관리 시스템 도입 필요성을 강조했다.
살모넬라균은 최근 6년간 국내에서 연평균 110~160건의 식중독 사고를 일으켰다. 미국도 예외는 아니다. 계란, 토마토, 고추 등을 매개로 수천 명의 감염 사례가 반복 발생했다. 하상도 중앙대 교수는 “살모넬라 등 세균성 식중독은 위생관리가 철저해도 완전 차단이 불가능하며, 글로벌 선도기업과 수출식품에서도 예외가 아니다”라고 지적했다.
문제는 콜드체인의 취약 지점이다. 일부 제과업체 유통 과정에서 냉동 케이크가 배송 후 2시간 이상 상온에 방치되는 사례가 적발되며 식품안전 사각지대가 드러났다. 소비자시민모임은 “정부가 식육이나 케이크 등 고위험 냉장식품의 유통 전반에 대해 실효성 있는 조치를 마련해야 한다”고 밝혔다.
이에 식품안전 전문가들은 디지털 기반 고도화를 대안으로 제시하고 있다. 한상배 한국식품안전인증원 원장은 “AI 기반 스마트 헷썹과 지능형 온도스티커(TTI) 등 기술을 도입해 유통 온도를 실시간 감시해야 한다”며 제도적 검토 필요성을 언급했다. 이재용 한국식품안전정보원 원장도 “AI·빅데이터 기반의 선제적 안전관리는 K-푸드 수출 지속성장의 필수요소”라고 말했다.
시장에서도 변화가 감지된다. 파리크라상, 성심당 등 선도 제빵업체들은 소비기한 도입과 스마트 해썹 구현을 시도하며 TTI 도입도 병행하고 있다. 전문가들은 이를 통해 국내 식품안전 수준 향상은 물론, 글로벌 K-푸드 신뢰도 제고 효과도 기대된다고 보고있다.
박효주 기자 phj20@etnews.com



















